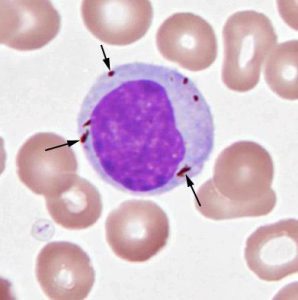

-
Team Homeopathy 360
Posts

Gujarat High Court Upholds NEET Requirement For Ayurveda, Homoeopathy Courses
AHMEDABAD: The Gujarat High Court today dismissed a petition challenging a rule which makes the National Eligibility cum Entrance Test (NEET) mandatory for admission to...

IMA Adopts New Logo, Traditional Med Practitioners See Red
The Indian Medical Association (IMA) has adopted a new logo to be used only by allopathic doctors across the country. The idea behind the...

Workshops: An Exclusive Mothers & Kids Exhibition: August 5, 2017
Dr. Rukshin Master will be conducting a workshop this Saturday : August 5, 2017 on ” Why Homoeopathy should be the first choice for a...

Psycho-physiological Reflections on Lachesis
(A paper read to the XXIX International Congress of Homoeopathic Medicine at Washington in June 1974) I have been away from these meetings for 15...

A HISTORY OF HOMOEOPATHY IN BRITAIN
Homeopathy was introduced into the UK by Dr Frederick Hervey Foster Quin (1799-1878) in the 1830’s, politically and socially the most volatile and turbulent decade of the...

Homoeopathy and Scar Tissue
Observations on the influence of certain potentized substances on scar tissue (Richard Hughes Memorial Lecture read to the Faculty of Homoeopathy on 28 March, 1974)...
Homoeopathy May Treat Malaria, Vitiligo Patients: Research
Hemozoin Homeopathy has shown the ability to treat malaria and vitiligo in lab models, says new research by Mumbai’s BMC-run BYL Nair Charitable Hospital and...

Approach to Pharmacy in Homoeopathy
When we talk about pharmacy as a subject usually thought revolve around collection, preparation and dispensing of medicinal substance in our mind. Preparing a substance...

AIAPGET 2017 – All India Ayush Post Graduate Entrance Test 2017 : August 6, 2017: Admit cards available
Follow at : http://www.aiapget.com/ [pdfjs-viewer url=”http%3A%2F%2Fwww.bjain.com%2Fhomeopathy360%2Fwp-content%2Fuploads%2F2017%2F08%2FAIAPGET_2017_BROCHURE.pdf” viewer_width=100% viewer_height=1360px fullscreen=true download=true print=true]


